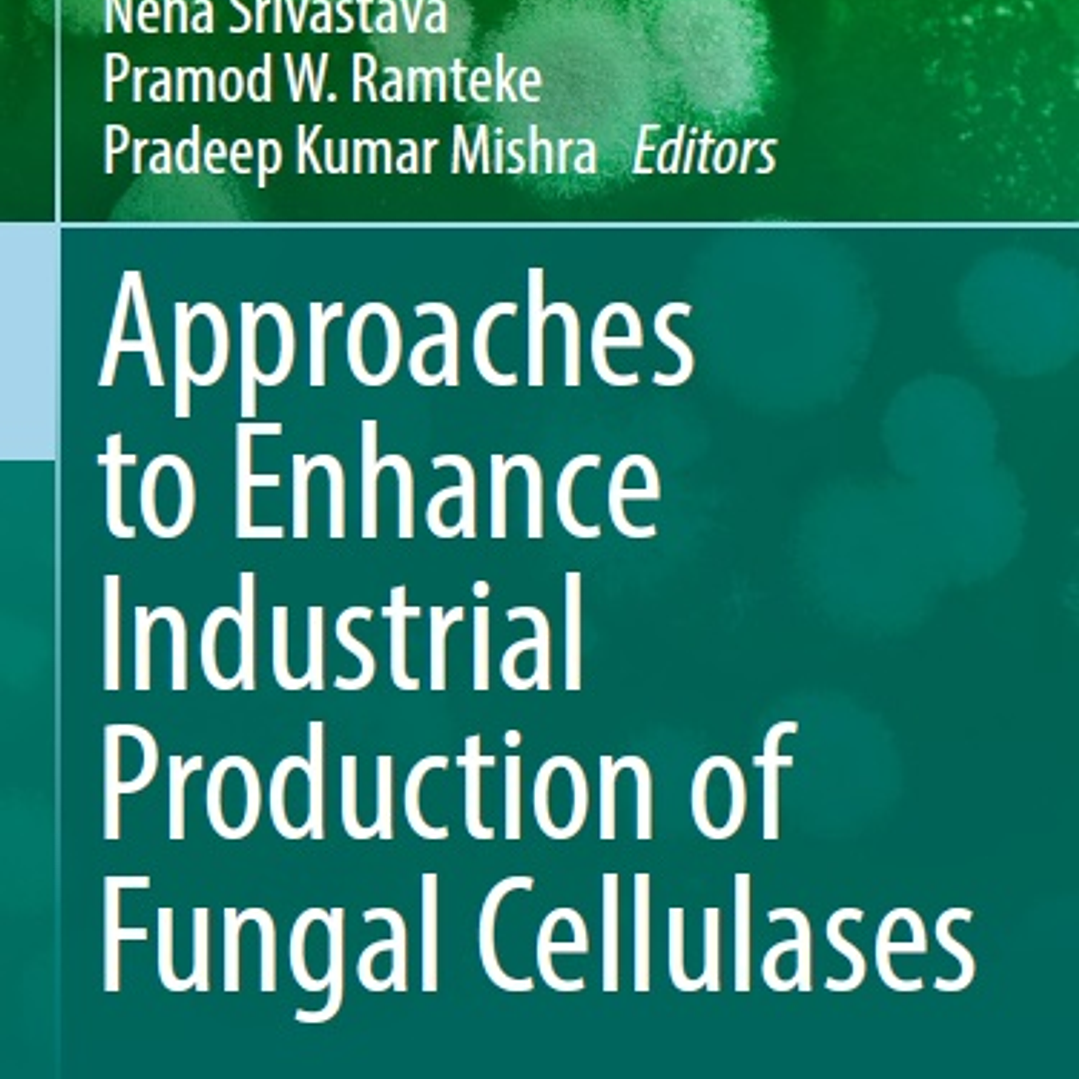

Approaches to Enhance Industrial Production of Fungal Cellulases
Description
(Fungal Biology) 1st ed. 2019 Edition
by Manish Srivastava (Editor), Neha Srivastava (Editor), Pramod W. Ramteke (Editor), Pradeep Kumar Mishra (Editor)
Cellulase is a key enzyme of industrial interest and plays a crucial role in the hydrolysis of cellulose, a prime component of plant cell walls. Cellulase covers a broad area in the global market of industrially important enzymes and it is considered as the third largest industrial enzyme globally. Additionally, cellulase contributes about 20% of the total enzyme market globally because of its massive demand in various industries such as in biofuel production, pulp, paper, textile, food, and beverages, as well as in detergent industries. Among these, the demand of cellulase may become frequently selected in the commercial production of biofuels in the future and thus will further increase demand of cellulase in the biofuel industry. Because biofuel production is still not realized in a cost-effective, practical implementation due to its high cost (the higher cost of biofuels is due to higher production costs of enzymes), there is a need to introduce these types of approaches, which will help to lower the cost of enzyme production for developing overall economic biofuel production.